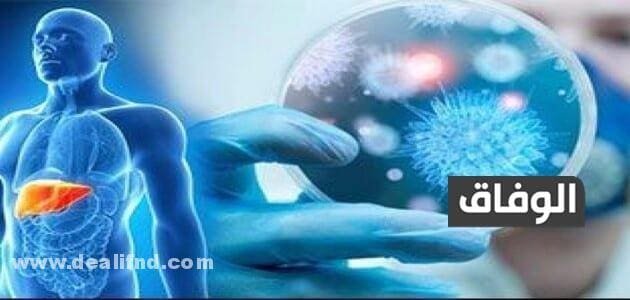
كمية الدم اللازمة لنقل فيروس سي

كمية الدم اللازمة لنقل فيروس سي وما لا تعرفة عن فيرس سي وأسبابه
كمية الدم اللازمة لنقل فيروس سي هي كمية معينة من الدم تحمل فيروس سي تنتقل من شخص إلى شخص أخرى، انتشر فيروس سي انتشارًا كبيرًا في الأعوام الأخيرة، وذلك لزيادة عدد المدمنين.
كمية الدم اللازمة لنقل فيروس سي:
ينتقل فيروس سي عن طريق كمية معينة من الدم، وهو يعتبر من الأمراض سريعة الانتشار والانتقال مثله مثل مرض الإيدز، ومن أهم عوامل انتشاره هو استخدام السرنجات، ونقل الدم، وبعض العوامل الأخرى ويعدان من أهم أسباب انتشار فيروس سي.
ما هو التهاب الكبد سي؟
هو التهاب كبدي وبائي ينتقل عن طريق الدم والمواد الكيميائية، والأدوية، والكحوليات، أوعن طريق الفيروسات الأخرى.
هل التهاب الكبد (سي) مثل التهاب الكبد (أ) التهاب الكبد (ب)؟
بالطبع لا؛ يختلف التهاب الكبد سي عن التهاب الكبد أ التهاب الكبد ب، فهم يعتبرون أنواع مختلفة من الفيروسات التي تصيب الكبد، الفيروس منهم له طرق مختلفة في الانتقال، يوجد تطعيم ضد التهاب الكبد أ التهاب الكبد ب ولكن لا يوجد تطعيم يقي من فيروس سي.
كيف تصاب بفيروس سي؟
كما ذكرنا من قبل أن فيروس سي ينتقل عن طريق الدم حتى لو كانت عينة صغيرة، يمكن أن تصاب بفيروس سي بالطرق الآتية:
- بعض الفحوصات الطبية التي تجري بدون تعقيم للأدوات مثل الأدوات الخاصة بالأسنان وتعتبر من العوامل المهمة في انتقال فيروس سي.
- استخدام السرنجات عدة مرات تعتبر على رأس الأسباب.
- القيام بعمل وشم بدون تعقيم الأدوات.
- يمكن أن ينتقل إلي الممرضين عن طريق الاستخدام الخاطئ للسرنجات.
- يمكن أن ينتقل من الأم إلى الطفل في أثناء فترة الحمل وأثناء الولادة أيضا.
- استخدام الأدوات الشخصية من شخص لآخر مثل أدوات الحلاق وفرش الأسنان.
- يمكن أن ينتقل عن طريق العلاقة الزوجية.
يوجد بعض الأشياء يعتقد الأفراد أن بإمكانها نقل فيروس سي وهي عكس ذلك وهما:
- الأدوات التي نتناول بها الطعام.
- استخدام المراحيض لجميع الأشخاص.
- الكحة، والعطس، والتقبيل.
- حمامات السباحة.
- الناموس والحشرات.
شاهد أيضا:-أعشاب طاردة للبلغم وموسع للشعب الهوائية
أعراض الإصابة بفيروس سي:
توجد بعض الأعراض التي قد يعانيها الأشخاص المصابون بفيروس سي أهمها ما يلي:
- حدوث نزيف.
- الإصابة بكدمات.
- التعب والأرق.
- شحوب في الوجه والعين.
- ألم في المعدة.
- التهاب المفاصل والعضلات.
- فقدان الشهية.
- غمقان في البول.
- حكة في الجلد.
- تورم الرجلين.
- التهاب الغدد اللعابية، جفاف الفم.
تشخيص فيروس سي:
يصف لك الطبيب بعض الفحوصات يجب اتباعها كالآتي:
- تشخيص فيروس سي عن طريق أخذ عينة دم من المريض ثم القيام بتحليل هذه العينة لوضوح إذا كان المريض مصاب بفيروس أو لا.
- يمكن أن يطلب الطبيب بإجراء خزعة من الكبد لمعرفة نسبة التليف في الكبد.
عوامل الخطر:
توجد بعض العوامل التي تزيد من الإصابة بفيروس سي هذه العوامل هي:
- إذا كنت من الممرضين الذين يتعرضون للدم الفاسد.
- عندما تقوم باستخدام السرنجات عدة مرات.
- إذا قمت بإجراء عمليات نقل دم أو زراعة أعضاء.
- إذا كنت من مرضى الغسيل الكلوي.
- عندما تكون طفلًا لأم مصابة بفيروس سي.
- السجن يعتبر بيئة لاستيطان فيروس سي فيه، فإن الدخول فيه يسبب لك الإصابة بالفيروس.
- إذا قمت بعمل وشم على الجلد.
- إذا قمت باستعمال الأدوات الخاصة بشخص مصاب بفيروس سي.
شاهد أيضا:-دواء للبرد سريع المفعول للاطفال الرضع
المضاعفات التي تحدث للمرضى المصابين بفيروس سي:
يوجد العديد من المضاعفات التي تحدث للمصابين بفيروس سي أهمها ما يلي:
- الإصابة بتندب الكبد الذي يعيقه من أداء وظيفته.
- الإصابة بسرطان الكبد وهذا يحدث لعدد قليل جدًا من المرضى المصابين بفيروس سي.
علاج فيروس سي :
يوجد بعض العلاجات اللازمة لتعافي من فيروس سي سنتناولها كالآتي:
- في بداية الإصابة بفيروس سي لا يتطلب علاج فقد تكون المناعة الاستجابية كفيلة بالقضاء عليه،
- أما إذا كان الالتهاب مزمنًا يجب أخذ العلاج اللازم للتخلص من الفيروس باستخدام مضادات للفيروسات إلي جانب أدوية أخرى مثل النمط الجيني للفيروس الكبدي سي.
- بعد الانتهاء من الكورس العلاجي يتم إجراء تحليل دم للمريض، إذا أظهر التحليل وجود نسبة فيروس فقد يطلب الطبيب بكورس علاجي آخر.
بعد أن تعرفنا على كمية الدم اللازمة لنقل فيروس سي وايضا تعرفنا على العلاج والفحوصيات اللازمة لمعرفة إذا كان شخص مصاب بالفيروس أو لا، وتعرفنا أيضا على عوامل الخطر ومن خلالها يمكن الوقاية من العوامل التي تزيد من الإصابة بفيروس سي.